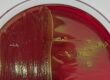

Dermatophyten sind weltweit verbreitete, keratinophile, fadenförmige Pilze, die Haut, Haare und Krallen befallen und aufgrund ihres zoonotischen Potentials eine ernst zu nehmende Rolle spielen (de Matos und Kalivoda 2013). Sie werden laut dem National Center for Biotechnology Information (NCBI, Bethesda, Maryland, USA) aktuell in 9 Genera (u. a. Microsporum, Trichophyton und Arthroderma) eingeteilt (Schoch et al. 2020). Microsporum spp. und Trichophyton spp. sind die Hauptursachen für Dermatophytosen beim Tier, vor allem bei Hunden und Katzen (Paryuni et al. 2020). Beim Kleinsäuger verursachen v. a. Hautpilze aus dem Trichophyton-benhamiae-Komplex (mehrere anthropophile und zoophile Arten), überwiegend Trichophyton (T.) benhamiae, selten Microsporum (M.) canis oder andere Arten (Tabelle 1) die sogenannte Ringflechte (Fréalle et al. 2007, ESCAPP 2021).
Die korrekte Benennung ist schwierig. Ursprünglich wurde T. benhamiae nach morphologischen Kriterien wie Wachstumsverhalten, Phänotyp (gelb/weiß) und mikroskopischem Aussehen klassifiziert und die anamorphe (asexuelle) Wuchsform zunächst T. mentagrophytes genannt (Fréalle et al. 2007). Durch DNA-Sequenzierung wurde die teleomorphe (sexuelle) Hauptform differenziert, wodurch es zu einer Umbenennung in Arthroderma (A.) benhamiae kam (Fréalle et al. 2007). Die aktuelle Bezeichnung seit 2017 ist T. benhamiae-Komplex (Hoog et al. 2017). In älteren Publikationen findet man entsprechend die Benennung T. mentagrophytes, in neuen T. benhamiae – beide beziehen sich aber also auf die gleiche Spezies.
Wer bekommt’s?
Am häufigsten infizieren sich Meerschweinchen und Igel mit Dermatophyten, andere Kleinsäuger eher selten (Tabelle 1).
Die Prävalenz von T. benhamiae variiert beim Meerschweinchen je nach Haltungsform. Bei einer Untersuchung von 59 Meerschweinchen aus 15 Berliner Zoohandlungen wurden 90 % (53/59) mittels PCR positiv getestet (Kupsch et al. 2017). In den Niederlanden lag die Prävalenz von T. mentagrophytes in Zoohandlungen bei 16,8 % (30/179) beim Meerschweinchen sowie 3,8 % (8/213) beim Kaninchen (Overgaauw et al. 2017).
-
Abb. 1: Junges Meerschweinchen mit typischer krustiger Läsion auf dem Nasenrücken bei Dermatophytose
Bildquelle: Dr. J. Hein
-
Abb. 2: Probenentnahme für die Dermatophytenuntersuchung mittels McKenzie-Brush
Bildquelle: Dr. J. Hein
Tab. 1: Vorkommen und Häufigkeit von Dermatophyten bei Kleinsäugern: **** häufig, ** selten, * sehr selten;
T.=Trichophyton, M.=Microsporum, N.=Nannizzia, A=Arthroderma; alte Benennung je nach Zeitpunkt der Veröffentlichung; Quellen: Berlin et al. 2020, de Matos und Kalivoda 2013, ESCCAP 2021, Kraemer et al. 2012, Overgaauw et al. 2017, Pignon und Mayer 2011, Vangeel et al. 2000
|
Tierart |
Dermatophyten |
|
Meerschweinchen |
T. benhamiae (T. mentagrophytes)****, M. canis*, N. gypsea (M. gypseum)*, T. equinum (M. equinum)*, M. audouinii*, A. quadrifidum (T. terrestre)* |
|
Kaninchen |
T. benhamiae (T. mentagrophytes)**, M. canis*, N. gypsea (M. gypseum)*, T. terrestre* |
|
Frettchen |
M. canis**, T. mentagrophytes** |
|
Chinchilla |
T. mentagrophytes**, Microsporum spp.* |
|
Ratte |
T. mentagrophytes** (v. a. asymptomatische Träger), Microsporum spp.* |
|
Maus |
T. mentagrophytes ** (v. a. asymptomatische Träger) |
|
Gerbil |
T. mentagrophytes **, N. gypsea (M. gypseum)* |
|
Hamster |
T. mentagrophytes**, Microsporum spp.* |
|
Afrikanischer Weißbauchigel |
T. erinacei**** M. canis*, N. gypsea (M. gypseum)* |
In einer weiteren, aktuellen, deutschen Studie bei Meerschweinchen wurden sowohl Zucht- als auch Heimtiermeerschweinchen untersucht (Berlin et al. 2020). Von insgesamt 21 privaten Zuchtbeständen wurden 68,8 % (262/381) der Tiere positiv auf Dermatophyten getestet – 55,4 % davon auf T. benhamiae, 13,4 % auf andere (7,1 % T. interdigitale, 6,0 % T. rubrum, 2,6 % T. erinacei, 2,3 % T. verrucosum, 1,3 % T. mentagrophytes). 92,7 % aller Tiere waren asymptomatische Träger. Geschlechtsabhängige Unterschiede konnten nicht festgestellt werden. Langhaarrassen mit Locken (74,0 %) sowie Rexmeerschweinchen (68,1 %) waren öfter betroffen als Kurzhaarrassen, Tiere in Innenhaltung (67,2 %) öfter als Tiere in Außenhaltung. Zuchten mit häufigerem Wechsel im Tierbestand (76,0 %) waren signifikant stärker mit T. benhamiae infiziert als Tiere aus autarken Zuchten (37,1 %) (Berlin et al. 2020). Auch wenn oft beschrieben ist, dass Dermatophyten bei Jungtieren häufiger vorkommen (de Matos und Kalivoda 2013, ESCCAP 2021, Kraemer et al. 2012), konnte dies in dieser Studie bei Meerschweinchen aus Zuchtbeständen nicht bestätigt werden (Berlin et al. 2020).
Bei der Auswertung der 9636 Laboruntersuchungen von Heimtiermeerschweinchen lag die Dermatophyten-Prävalenz bei 3,9 % (382/9636), bei Tieren mit klinischem Verdacht bei 36,9 % (382/1035). T. benhamiae wurde bei 98,2 % der Tiere mit klinischem Verdacht nachgewiesen (Berlin et al. 2020).
Eine weitere deutsche Studie von 2012 untersuchte ebenfalls die Prävalenz von Dermatophyten bei Laboreinsendungen von Heimtiermeerschweinchen mittels kultureller Untersuchung (Kraemer et al. 2012). Bei 38,1 % (431/1132) der Heimtiermeerschweinchen konnten Dermatophyten festgestellt werden, in 91,6 % (395/431) davon T. mentagrophytes. Zusätzlich wurden gesunde Meerschweinchen beprobt: 8,5 % (14/164) waren asymptomatische Träger (Kraemer et al. 2012). Die Prävalenzen beim Heimtiermeerschweinchen sind also annährend gleich hoch geblieben.
Heimtierkaninchen hingegen zeigten in der Laborprobenauswertung von 2012 nur in 8,1 % (83/1021) Dermatophyten, in 72,3 % davon (60/83) T. mentagrophytes. Asymptomatische Träger bei gesunden Kaninchen gab es in dieser Studie nicht (0/140) (Kraemer et al. 2012). In einer belgischen Studie waren 3,8 % (4/104) der Heimtier-, Zucht- und Laborkaninchen asymptomatische Träger (Vangeel et al. 2000). In der deutschen Studie waren Kaninchen mit positiver Pilzkultur jünger als Tiere mit negativer Pilzkultur oder gesunde Tiere (Kraemer et al. 2012).
Bei Igeln werden Dermatophytosen häufig durch T. erinacei, sehr selten durch M. canis und Nannizzia (N.) gypsea (M. gypseum) verursacht (Pignon und Mayer 2011). Bei klinisch auffälligen Tieren konnte bei 4 von 5 Tieren T. erinacei diagnostiziert werden. Asymptomatische Trägertiere sind mit 11,5 % (47/408) beschrieben (Pignon und Mayer 2011).
Dermatophyten kommen bei Meerschweinchen häufig, bei Kaninchen selten vor. Meerschweinchen aus Zoohandlungen (bis 90 %) und privaten Zuchtbeständen (68,8 %) sind deutlich stärker betroffen als Heimtiermeerschweinchen (bis 38,1 %). Die Prävalenz bei asymptomatischen Meerschweinchen variiert je nach Haltung zwischen 3,9 % (Heimtiere) und 92,7 % (Zuchtbestände).
Wer überträgt’s?
Dermatophytosen sind Zoonosen! Übertragungen auf den Menschen sind häufig beschrieben. Während der Coronapandemie ist die Zahl von humanen T. benhamiae-Infektionen entsprechend der zunehmenden Haltung von Kleintieren in dem Zeitraum gestiegen (Uhrlaß et al. 2023). Überwiegend sind Kinder und Jugendliche betroffen, was auf einen oft engen Kontakt mit den Haustieren zurückzuführen ist. Gefährlich kann eine Infektion für immunsupprimierte Menschen werden (Nationale Forschungsplattform für Zoonosen 2020).
Die häufigste Quelle für humane Infektionen stellen Meerschweinchen dar (Berlin et al. 2020, Kupsch et al. 2017, Nationale Forschungsplattform für Zoonosen 2020, Nenoff et al. 2014, Uhrlaß et al. 2023).
Aber auch Kaninchen können zu potentiellen Gefahrenquellen werden. In 27,3 % (3/11) der betroffenen Haushalte mit Dermatophyten-positiven Heimtierkaninchen waren die Besitzer, hier v. a. die Kinder, infiziert (Krämer et al. 2012). Auch eine Übertragung von Dermatophyten durch Europäische Igel und Afrikanische Weißbauchigel auf den Menschen kommt vor (Pignon und Mayer 2011, Riley und Chomel 2005).
Die Übertragung von Dermatophyten findet direkt und indirekt über mit Sporen kontaminierte Gegenstände, Einstreu, Bürsten und Kämme statt (de Matos und Kalivoda 2013, ESCCAP 2021). Infizierte Frettchen leben oft mit Katzen zusammen (de Matos und Kalivoda 2013). Igel infizieren sich vermutlich über direkten Kontakt bei der Mutter oder bei Kämpfen und Balzverhalten, da die Veränderungen oft am Kopf auftreten (Pignon und Mayer 2011). Hohe Tierzahlen auf engem Raum erhöhen den Infektionsdruck (Berlin et al. 2020, de Matos und Kalivoda 2013).
Zur klinischen Manifestation kommt es oftmals bei Immunsuppression bedingt durch Stress, andere Grunderkrankungen, Parasitenbefall, Absetzen im Jungtieralter sowie warmes, feuchtes Klima.
Infektionsbegünstigend sind Verletzungen, Risse in der Haut und erhöhte Hautfeuchtigkeit (Berlin et al. 2020).
Typische klinische Symptome sind kreisrunde Alopezie, abgebrochene Haare, Schuppen, Erytheme, gelbe Krusten, zum Teil Juckreiz (de Matos und Kalivoda 2013). Initial beginnen Dermatophytosen oft am Kopf (Nasenrücken, Augenlidern und Pinnae) (Abbildung. 1). Oftmals kommt es zu sekundärer Pyodermie und zu einer Weiterverteilung auf (Vorder-)Pfoten, Krallenbett und später auf den ganzen Körper (de Matos und Kalivoda 2013). Bei Igeln kommt es oft zu nicht juckenden, schuppigen Läsionen, v. a. am Kopf und zum Stachelverlust (de Matos und Kalivoda 2013, Pignon und Mayer 2011).
Wie diagnostizieren?
Proben für eine mykologische Diagnostik entnimmt man am besten nach der McKenzie-Hairbrush-Technik (Abbildung. 2). Um die Sensitivität zur erhöhen wird das gesamte Tier, nicht nur die veränderten Hautareale, 1 – 2 Minuten mit einer sterilen Bürste (Zahnbürste, Zytobrush) abgebürstet (Berlin und Gräser 2020). Zusätzlich sollten einige Haare samt Wurzel vom Übergang der veränderten Hautbereiche entnommen und in einer verschließbaren Tüte oder einem Gefäß eingesandt werden.
Mittels mikroskopischer Untersuchung (z. B. Trichogramm) können mikroskopisch Pilzhyphen oder -sporen an und/oder in den Haaren nachgewiesen werden. Ein negativer Befund schließt eine Infektion jedoch nicht aus. Mit Hilfe der Wood’schen Lampe kann nur eine Infektion mit M. canis nachgewiesen werden. Allerdings zeigt sich eine Fluoreszenz nur bei ca. 50 % der Infektionen. Die Fluoreszenz entsteht durch in die Haarfollikel eingelagerte Metaboliten, die während einer Infektion gebildet werden und kann i. d. R. 7 – 14 Tage nach Infektion nachgewiesen werden (Moriello et al. 2017). Falsch positive Ergebnisse können z. B. durch Fusseln, topische Medikamente oder sogar Seifenreste hervorgerufen werden (Moriello et al. 2017).
Der Nachweis mittels mykologischer Kultur erfolgt durch Anzucht auf Spezialnährmedien mit nachfolgender makroskopischer und mikroskopischer Differenzierung. Um eine Überwucherung mit Schimmelpilzen zu vermeiden, ist es sinnvoll, das Fell vor Probenentnahme mit einem alkoholfeuchten Tuch abzustreifen. Zusätzlich werden im Labor Selektivnährmedien verwendet, die das Wachstum von Kontaminanten unterdrücken sollen. Die Dauer der mykologischen Kultur ist unterschiedlich, positive Befunde können oft bereits innerhalb 1 Woche vorliegen. Im negativen Fall wird die Kultur in der Regel 3 – 4 Wochen inkubiert, um ein Wachstum auszuschließen.
Das nationale Konsiliarlabor für Dermatophyten empfiehlt aufgrund der schnelleren Analysedauer von nur 2 – 3 Tagen den Nachweis mittels PCR. Eine Differenzierung der Spezies ist möglich. Da die PCR auch abgestorbene Sporen detektiert, ist eine Therapiekontrolle mittels PCR entsprechend nur nach gründlichem Entfernen der Sporen durch Badetherapie sinnvoll und sollte bei der Interpretation der Ergebnisse bedacht werden. Daher wird zur Therapiekontrolle die Pilzkultur empfohlen (ESCCAP 2009). Die histologische Untersuchung einer Hautbiopsie mittels Spezialfärbung liefert ein Ergebnis ebenfalls innerhalb weniger Tage. Sie ist jedoch nur im positiven Fall beweisend, invasiv und daher kein Diagnostikum der Wahl (Weider 2015).
Welches Verfahren am sensitivsten ist, hängt von der Klinik, der Probenentnahme und der Studie ab. Neuere Untersuchungen zeigten bei sichtbaren Dermatophytenläsionen eine hohe Sensitivität der Mikroskopie gefolgt von der PCR (Gnat et al. 2022). Bei asymptomatischen Tieren ist meist die PCR überlegen (Berlin und Gräser 2020, Nikaein et al. 2023). In der neusten Fachliteratur wird allerdings empfohlen, für ein sicheres Ergebnis PCR und Kultur zu kombinieren (Frost et al. 2022).
Therapie
Die Therapie von Dermatophytosen sollte nach aktueller ESCCAP-Empfehlung erfolgen (Kombination von systemischer [Itraconazol] und Badetherapie [Enilconazol 2 × wöchentlich]) (Berlin und Gräser 2020, ESCCAP 2009, Hein 2016, Körnig 2021). Die Badelösung wird nicht ausgewaschen. Um vor Unterkühlung zu schützen, sollten die Tiere nach Waschbehandlungen entsprechend in ein Handtuch gewickelt werden. Eine alleinige lokale Behandlung betroffener Hautstellen ist wegen des hohen Zoonoserisikos, das auch von asymptomatischen Tieren ausgeht, strikt abzulehnen (Berlin und Gräser 2020, ESCCAP 2009, Hein 2016, Körnig 2021).
Alle Tiere im Bestand sind unabhängig vom klinischen Bild zu behandeln! Die Therapie endet optimalerweise nach 2 negativen Kontrollen. Eine Umgebungsbehandlung (Käfig, Häuschen, Pflegeutensilien, Kleidung etc.) parallel zu den Badebehandlungen ist zwingend notwendig. Schlecht zu desinfizierende Käfigeinrichtung sollte für den Zeitraum der Therapie gegen Pappkartons etc. ausgetauscht werden.
Eine Testung vor Einbringen neuer Tiere in den Bestand ist besonders bei den häufig subklinisch infizierten Meerschweinchen indiziert (ESCCAP 2009).
Fazit
Dermatophyten können bei fast allen Kleinsäugern vorkommen, sind jedoch nur beim Meerschweinchen und Igel häufig. Da gerade asymptomatische Meerschweinchen Hauptüberträger für humane Infektionen v. a. bei Kindern sind, sollte bei Neukauf getestet werden. Eigenschutz ist wichtig und darf nicht vernachlässigt werden.
Jana Liebscher, Dr. Jutta Hein
Weiterführende Literatur
-
Berlin M, Gräser Y. Leitfaden – Dermatophytose beim Meerschweinchen. Herausgegeben durch das nationale Konsiliarlabor für Dermatophyten, Institut für Mikrobiologie und Infektionsimmunologie, Charité – Universitätsmedizin
-
Berlin [Internet]2020. Available from: https://imh.charite.de/fileadmin/user_upload/microsites/ m_cc05/imh/Medien/Bilder/Leitfaden_Dermatophytose_beim_Meerschweinchen.pdf
-
Berlin M, Kupsch C, Ritter L, Stoelcker B, Heusinger A, Gräser Y. German-Wide Analysis of the Prevalence and the Propagation Factors of the Zoonotic Dermatophyte Trichophyton benhamiae. Journal of Fungi; 2020; 6(3):161. doi:10.3390/jof6030161
-
de Matos und Kalivoda. Dermatoses of Exotic Small Mammals. In: Miller W, Griffin C, Campbell K, editors. Muller & Kirk’s Small Animal Dermatology. 7. St. Louis (MO): Elsevier; 2013. p. 844–87.
-
ESCCAP. Bekämpfung von Dermatophytosen bei Hunden und Katzen. Deutsche Adaption der ESCCAPEmpfehlung Nr. 7, Februar 2009 [Internet]2009. https://www.esccap.de/v2/wp-content/uploads/2020/06/2- 2022-Dermatophyten-Empfehlung-2.pdf
-
ESCCAP. Empfehlungen zur Behandlung von Parasiten und Mykosen bei kleinen Heimtieren (Kleinsäugern). Deutsche Adaption der ESCCAP-Empfehlung Nr. 7, Erste Ausgabe – Juni 2021 [Internet]2021. https://www. esccap.de/v2/wp-content/uploads/2021/06/Web-07-2021-Heimtiere-GL_DE.pdf
-
Fréalle E, Rodrigue M, Gantois N, Aliouat C-M, Delaporte E, Camus D, Dei-Cas E, Kauffmann-Lacroix C, Guillot J, Delhaes L. Phylogenetic analysis of Trichophyton mentagrophytes human and animal isolates based on MnSOD and ITS sequence comparison. Microbiology (Reading); 2007; 153(Pt 10):3466–77. doi:10.1099/ mic.0.2006/004929-0
-
Frost K, Schick A, Mount R. A retrospective analysis of the concordance of in-house fungal culture and a commercial quantitative PCR from 16 dermatology referral practices across the USA (2018-2019). Vet Dermatol; 2022; 33(5):392–7. doi:10.1111/vde.13085
-
Gnat S, Łagowski D, Dyląg M, Nowakiewicz A. European Hedgehogs (Erinaceus europaeus L.) as a Reservoir of Dermatophytes in Poland. Microb Ecol; 2022; 84(2):363–75. doi:10.1007/s00248-021-01866-w
-
Hein J. Dermatophytose bei Kaninchen und Meerschweinchen – ein Update einer Zoonose. Kleintierpraxis; 2016; 12:675–88. doi:10.2377/0023-2076-61-675
-
Hoog GS de, Dukik K, Monod M, Packeu A, Stubbe D, Hendrickx M, Kupsch C, Stielow JB, Freeke J, Göker M, Rezaei-Matehkolaei A, Mirhendi H, Gräser Y. Toward a Novel Multilocus Phylogenetic Taxonomy for the Dermatophytes. Mycopathologia; 2017; 182(1-2):5–31. doi:10.1007/s11046-016-0073-9
-
Körnig J. Hautpilze beim Meerschweinchen im Wandel – eine neue Herausforderung in der kulturellen Diagnostik. Der Praktische Tierarzt; 2021(102):1178–91. doi:10.2376/0032-681X-2151 Kraemer A, Mueller RS, Werckenthin C, Straubinger RK, Hein J. Dermatophytes in pet Guinea pigs and rabbits. Veterinary Microbiology; 2012; 157(1-2):208–13. doi:10.1016/j.vetmic.2011.12.005
-
Krämer A, Müller RS, Hein J. Risikofaktoren, klinisches Bild, Therapie und Zoonoserisiko bei Kaninchen mit Dermatophytose. Tierarztl Prax Ausg K Kleintiere Heimtiere; 2012; 40(06):425–31. doi:10.1055/s-0038-1623669
-
Kupsch C, Berlin M, Gräser Y. Dermatophyten und Meerschweinchen: Eine unterschätzte Gefahr? Die Dermatologie; 2017; 68(10):827–30. doi:10.1007/s00105-017-4009-1
-
Moriello KA, Coyner K, Paterson S, Mignon B. Diagnosis and treatment of dermatophytosis in dogs and cats.: Clinical Consensus Guidelines of the World Association for Veterinary Dermatology. Vet Dermatol; 2017; 28(3):266-e68. doi:10.1111/vde.12440 Seite 2 von 2
-
Nationale Forschungsplattform für Zoonosen. Zoonose des Monats – Dezember 2020 Erregersteckbrief Trichophyton benhamiae [Internet]: Nationale Forschungsplattform für Zoonosen. 2020. https://zoonosen.net/ sites/default/files/redaktion/dateien/Erregersteckbrief_tbenhamiae_Dez2020_PDF_0.pdf
-
Nenoff P, Uhrlaß S, Krüger C, Erhard M, Hipler U-C, Seyfarth F, Herrmann J, Wetzig T, Schroedl W, Gräser Y. Trichophyton species of Arthroderma benhamiae – a new infectious agent in dermatology. JDDG: Journal der Deutschen Dermatologischen Gesellschaft; 2014; 12(7):571–81. doi:10.1111/ddg.12390
-
Nikaein D, Yaghuti P, Sharifzadeh A, Khosravi A, Balal A. Descriptive epidemiology of dermatophytosis in rodents. Vet Med and Sci; 2023; 9(1):167–73. doi:10.1002/vms3.1044
-
Overgaauw PAM, van Avermaete KHA, Mertens CARM, Meijer M, Schoemaker NJ. Prevalence and zoonotic risks of Trichophyton mentagrophytes and Cheyletiella spp. in guinea pigs and rabbits in Dutch pet shops. Veterinary Microbiology; 2017; 205:106–9. doi:10.1016/j.vetmic.2017.05.008
-
Paryuni AD, Indarjulianto S, Widyarini S. Dermatophytosis in companion animals: A review. Vet World; 2020; 13(6):1174–81. doi:10.14202/vetworld.2020.1174-1181
-
Pignon C, Mayer J. Zoonoses of ferrets, hedgehogs, and sugar gliders. Veterinary Clinics: Exotic Animal Practice; 2011; 14(3):533-49, vii. doi:10.1016/j.cvex.2011.05.004
-
Riley PY, Chomel BB. Hedgehog zoonoses. Emerg Infect Dis; 2005; 11(1):1–5. doi:10.3201/eid1101.040752 Schoch CL, Ciufo S, Domrachev M, Hotton CL, Kannan S, Khovanskaya R, Leipe D, Mcveigh R, O’Neill K,
-
Robbertse B, Sharma S, Soussov V, Sullivan JP, Sun L, Turner S, Karsch-Mizrachi I. NCBI Taxonomy: a comprehensive update on curation, resources and tools. Database (Oxford); 2020. doi:10.1093/database/baaa062
-
Uhrlaß S, Mayser P, Koch D, Mütze H, Krüger C, Schulze I, Nenoff P. Zoophile Dermatophyten während der Corona-Pandemie in Deutschland. Dermatologie (Heidelb); 2023:1–10. doi:10.1007/s00105-023-05150-5
-
Vangeel I, Pasmans F, Vanrobaeys M, Herdt P de, Haesebrouck F. Prevalence of dermatophytes in asymptomatic guinea pigs and rabbits. Veterinary Record; 2000; 146(15):440–1. doi:10.1136/vr.146.15.440
-
Weider K. Dermatophytose: Vor- und Nachteile diagnostischer Möglichkeiten. kleintier konkret; 2015; 18(01):44–5. doi:10.1055/s-0034-1384341